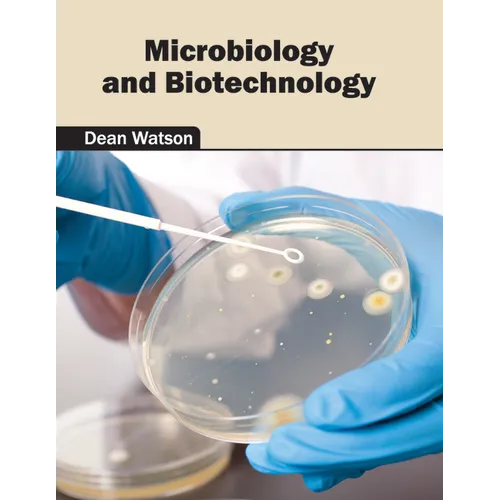
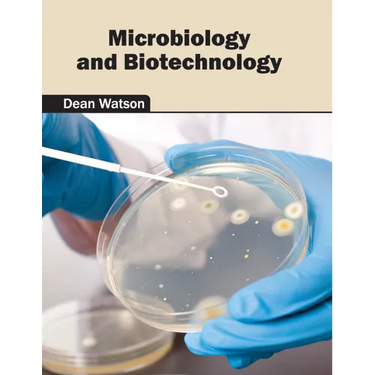

Microbiology and Biotechnology - Hardcover
 Microbiology and Biotechnology - Hardcover
$156.99
/
Microbiology and Biotechnology - Hardcover
$156.99
/

Your payment information is processed securely. We do not store credit card details nor have access to your credit card information.
by Dean Watson (Editor)
Biotechnology plays a vital role across various industries to develop and manufacture products that involve biological systems and organisms. Microbial organisms are widely used in food processing and pharmaceutical industries. They are also utilized in distinct industrial processes like fermentation and waste water treatment. Some of the diverse topics encompassed within this book are microbial cell biology, environmental microbiology and engineering, genetics, enzymology, applied genetics, etc. The topics in this book are compiled by internationally renowned panel of authors and industry experts. It will serve as a reference to a broad spectrum of readers.